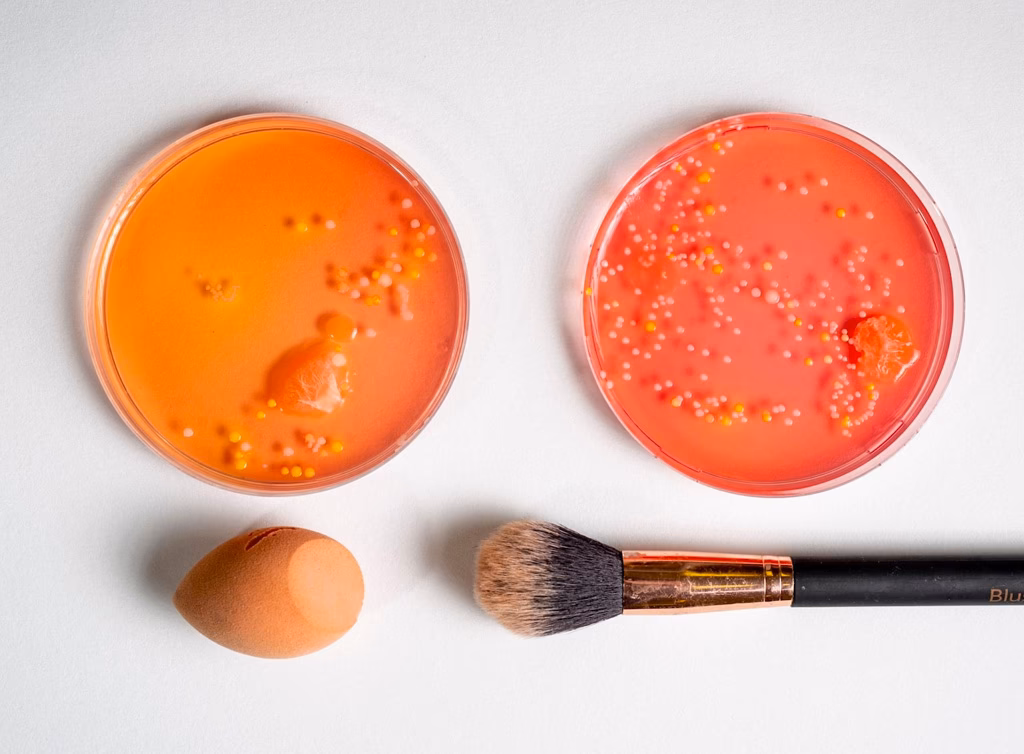

08/04/2025
Tu neceser de maquillaje guarda tus herramientas secretas para realzar tu belleza, pero ¿sabías que también puede ser un caldo de cultivo para huéspedes no deseados? Más allá de los colores y texturas, tus productos y aplicadores pueden albergar una variedad de microbios y contener ingredientes que quizás te sorprenderían. Cuidar tu piel y tu salud implica prestar atención a lo que aplicas en ella y cómo lo haces. Es hora de abrir tu bolsa de maquillaje y enfrentar la realidad de lo que podría estar oculto.
Con el tiempo, los conservantes presentes en los productos pueden degradarse, abriendo la puerta al crecimiento de bacterias y hongos. Si bien los productos con probióticos para la piel son beneficiosos, no debemos ignorar los microorganismos dañinos que pueden acechar en nuestras herramientas y cosméticos. Un estudio reciente de la Universidad de Aston en el Reino Unido reveló que entre el 79% y el 90% de los productos cosméticos usados, incluyendo labiales, brillos, delineadores, máscaras de pestañas y esponjas de maquillaje, estaban contaminados con una variedad de microbios potencialmente peligrosos. Estos incluían organismos patógenos como Staphylococcus aureus, Escherichia coli y Citrobacter freundii, que pueden representar riesgos graves para la salud, como infecciones cutáneas.
Los Microbios Invisibles en Tu Neceser
Los microorganismos, como bacterias y hongos, pueden llegar a tus productos y herramientas de maquillaje de diversas maneras. Aunque muchos de estos microbios ya viven en la superficie de nuestra piel sin causar problemas, pueden volverse dañinos si ingresan al cuerpo, por ejemplo, a través de una herida. Aplicar cosméticos cargados de bacterias sobre piel con cortes, rasguños, quemaduras, eccemas o simplemente seca y agrietada aumenta significativamente el riesgo de infección.
El estudio de Aston University destacó que la contaminación cosmética es un problema generalizado. La presencia de microorganismos como Staphylococcus aureus y E. coli en productos de uso común es alarmante. Estos microbios no solo provienen de la piel, sino también del ambiente. ¿Alguna vez has bajado la tapa del inodoro con tus brochas cerca? Las partículas fecales pueden llegar a ellas. Compartir maquillaje o herramientas con otras personas es otra vía directa para el intercambio de microbios diferentes a los tuyos.
Además, las bacterias responsables de los brotes de acné pueden transferirse fácilmente de tu piel a una brocha o esponja. Y no olvidemos a los diminutos ácaros llamados Demodex, que viven en la piel y también pueden terminar en tus aplicadores.
Productos Específicos con Mayor Riesgo
Ciertos productos y áreas de aplicación son especialmente preocupantes. La Administración de Alimentos y Medicamentos de EE. UU. (FDA) señala que muchas mujeres desarrollan infecciones oculares a causa de sus cosméticos cada año, y en casos raros, esto puede llevar a ceguera temporal o permanente. Brochas de sombras, varitas de máscara de pestañas y delineadores, si no se limpian y reemplazan regularmente, acumulan bacterias, aumentando la probabilidad de infección ocular con cada uso.
Los brillos labiales y labiales presentan el riesgo adicional de ingestión oral. Dado que el área de la boca es propensa a grietas, aftas y herpes labial, la penetración de microbios más allá de las capas externas de la piel es una preocupación. Es crucial evitar aplicar productos labiales sobre heridas en la piel y desechar los cosméticos viejos de labios.
Herramientas de Maquillaje: Un Foco de Contaminación
La mayoría de las personas reutilizan sus brochas y esponjas de maquillaje una y otra vez. Esta exposición repetida a tus manos y rostro convierte a estas herramientas en puntos clave de contaminación. Lavarse las manos antes de maquillarse es fundamental, al igual que lavar las herramientas.
En el estudio de Aston University, las esponjas de maquillaje (blenders) mostraron los niveles más altos de bacterias dañinas. Los investigadores descubrieron que el 93% de las esponjas nunca se habían limpiado, y el 64% se habían caído al suelo en algún momento y, aun así, se seguían utilizando. Esto subraya la importancia crítica de la limpieza regular y adecuada de las herramientas.
La Vida Útil de Tus Productos y Herramientas
Como mencionamos, los conservantes se degradan con el tiempo, permitiendo el crecimiento microbiano. Usar cosméticos viejos aumenta el riesgo de infección. Lamentablemente, una encuesta reciente reveló que casi el 98% de los participantes usan maquillaje después de su fecha de vencimiento, siendo la máscara de pestañas el producto más mencionado.
A diferencia de la Unión Europea, Estados Unidos no exige que los fabricantes de cosméticos listen una fecha de vencimiento. Algunas compañías usan voluntariamente símbolos PAO (Period After Opening) que indican cuánto tiempo es seguro usar un producto una vez abierto. En ausencia de fechas de vencimiento claras, algunos expertos sugieren desechar los cosméticos después de tres o cuatro meses. La máscara de pestañas debería reemplazarse cada dos o tres meses. Otros productos de belleza no deberían conservarse por más de seis a doce meses como máximo. Las esponjas de maquillaje, por su naturaleza porosa y húmeda tras el uso, deberían lavarse después de cada aplicación y desecharse cada tres meses.
La higiene de brochas y esponjas también es vital al probar maquillaje en mostradores y salones de belleza. Un estudio encontró Staphylococcus aureus en todas las brochas y esponjas de estos lugares, y entre el 70% y el 82% estaban contaminadas con Pseudomonas aeruginosa. La causa principal fue el uso repetido en clientes sin limpieza ni reemplazo. Optar por aplicadores de un solo uso en estos casos reduce la exposición a estos microbios.
Cómo Mantener Tu Kit Libre de Microbios
La limpieza regular de tus herramientas de belleza es tu principal defensa contra los microbios dañinos. Aquí te detallamos cómo hacerlo:
- Brochas: Lava tus brochas de maquillaje semanalmente con un champú suave. Enjuágalas hasta que el agua salga clara. Después, sumérgelas en una solución de una parte de vinagre por dos de agua. El vinagre es un bactericida natural de amplio espectro.
- Esponjas: Las esponjas de maquillaje deben lavarse después de cada uso debido a su alta propensión a acumular bacterias. Deséchalas cada tres meses.
- Secado: Asegúrate de que tanto esponjas como brochas se sequen completamente después de lavarlas. La humedad es un caldo de cultivo ideal para el crecimiento microbiano. Guárdalas en un lugar seco y limpio, lejos de fuentes de agua y, definitivamente, no cerca de un inodoro abierto.
- No Compartas: Nunca compartas tus brochas o esponjas de maquillaje. Cada persona tiene microbios distintos en su piel, y compartir herramientas es compartir esos microbios. Si necesitas compartir maquillaje, usa aplicadores desechables o asegúrate de que las herramientas compartidas se laven y esterilicen antes del siguiente uso.
- Limpieza Profunda: Puedes usar jabón bactericida, alcohol isopropílico al 70% o soluciones de clorhexidina para una limpieza más profunda. Asegúrate de enjuagar muy bien con agua caliente después, ya que estos productos pueden irritar la piel.
- Pruebas en Tiendas: Al probar maquillaje en tiendas, opta siempre por los aplicadores desechables individuales.
¿Deberías usar agua micelar para limpiar tus brochas? No. Además de ser costoso, es innecesario. Puedes lograr los mismos beneficios con detergentes más económicos o alcohol, siempre enjuagando bien después.
Más Allá de los Microbios: Otros Ingredientes Sorprendentes
Además de los invisibles microorganismos, algunos cosméticos pueden contener ingredientes cuya procedencia o naturaleza podrían parecer poco convencionales o incluso desagradables. Si bien las formulaciones buscan embellecer, a veces los componentes individuales son menos atractivos. Conocer estos ingredientes es importante para tomar decisiones informadas sobre los productos que usamos.
Es un recordatorio valioso de que solicitar ingredientes naturales o derivados de la naturaleza puede llevar a que provengan de fuentes inesperadas.
Ingredientes de Origen Animal y Humano
- Cochinilla (Carmín): Si ves 'carmine' en la lista de ingredientes, significa que el color rojo proviene de escarabajos de cochinilla triturados. Estos insectos son nativos de México y se muelen para liberar su vibrante tinte rojo. Se necesitan aproximadamente 70,000 insectos para producir medio kilo de tinte, lo que plantea cuestiones éticas para veganos.
- Baba de Caracol: Algunas cremas antiedad contienen la sustancia gelatinosa que dejan los caracoles al moverse. Esta secreción mucosa se comercializa principalmente para tratar el acné, curar cicatrices y quemaduras, y como hidratante profundo.
- Prepucio de Bebé: Los prepucios infantiles contienen una proteína llamada factor de crecimiento epidérmico (EGF) que se utiliza en tratamientos antiedad de alta gama para reafirmar la piel. El EGF puede formularse usando otros ingredientes, o derivarse de tejidos humanos como piel y riñones, y células madre clonadas a partir de prepucios de recién nacidos para uso cosmético.
- Aceite de Vison (Mink Oil): Usado en cosméticos y productos capilares desde los años 50. Se obtiene rindiendo la grasa de un cadáver de visón, que luego se purifica, blanquea y desodoriza. Aunque la investigación muestra que no es más efectivo que un aceite vegetal, se sigue usando en pequeñas cantidades.
- Ámbar Gris: Un fijador tradicional en perfumes caros. Es una sustancia cerosa negra expulsada por los cachalotes que flota en el océano y se solidifica. Aunque la investigación moderna sugiere que se excreta, muchos aún lo llaman "vómito de ballena". Ha sido valioso durante milenios, aunque su comercio internacional aún es legal (no en EE. UU.), existe preocupación por la disminución de la población de cachalotes.
- Sebo (Tallow): Una sustancia grasa dura hecha de un cadáver de vaca rendido. Aunque no tóxico para la salud humana, es un problema para veganos. Derivados como Sodium Tallowate o Tallow Acid pueden encontrarse en productos. También se considera un posible tóxico ambiental.
Ingredientes Sintéticos con Impacto
- Plástico: Aparece en cosméticos en varias formas. El Teflón, conocido por los sartenes antiadherentes, se ha encontrado en bases, protectores solares, sombras de ojos, bronceadores, etc. También aparece en forma de microesferas (microbeads) que actúan como exfoliantes. A pesar de alternativas naturales (azúcar, sal), se usan. Las microesferas están prohibidas en varios países y estados de EE. UU., pero no siempre cubren todos los productos (maquillaje, brillos). Evita productos con 'polyethylene' y 'polypropylene'.
Aquí tienes una tabla resumen de algunos de estos ingredientes menos convencionales:
| Ingrediente | Origen Común | Uso Principal en Cosmética |
|---|---|---|
| Carmín | Escarabajos de cochinilla triturados | Colorante rojo |
| Baba de Caracol | Secreción de caracol | Tratamiento acné, cicatrices, hidratación |
| Prepucio de Bebé | Tejido humano (clonado) | Factor de crecimiento epidérmico (EGF) antiedad |
| Aceite de Vison | Grasa de visón rendida | Emoliente, acondicionador |
| Ámbar Gris | Secreción/Excreción de cachalote | Fijador de perfume |
| Sebo | Grasa de vaca rendida | Base para jabones y otros derivados |
| Plástico (Teflón, Microesferas) | Polímeros sintéticos | Textura, exfoliación, antiadherente |
Preguntas Frecuentes
¿Pueden los bichos (microbios) vivir en mis brochas de maquillaje?
Sí, tus brochas y esponjas son superficies donde bacterias, hongos e incluso ácaros pueden acumularse con el uso regular y la exposición al ambiente y tu piel.
¿Con qué frecuencia debo limpiar mis brochas y esponjas?
Se recomienda lavar las brochas al menos semanalmente. Las esponjas, idealmente, después de cada uso debido a su porosidad y humedad.
¿Qué pasa si comparto mis herramientas de maquillaje?
Compartir brochas o esponjas significa intercambiar los microbios que cada persona tiene en su piel, aumentando el riesgo de infecciones cruzadas.
¿Puedo usar agua micelar para limpiar mis brochas?
No es lo más recomendado. El agua micelar no es un desinfectante eficaz para las herramientas y puede ser costoso. Es mejor usar jabón suave, champú o soluciones desinfectantes adecuadas.
¿Por qué caduca mi maquillaje?
Los conservantes en los productos se degradan con el tiempo, lo que permite que las bacterias y hongos crezcan, haciendo que el producto ya no sea seguro ni efectivo.
¿Qué ingredientes extraños puedo encontrar en el maquillaje?
Algunos ingredientes sorprendentes incluyen carmín (de insectos), baba de caracol, aceite de visón, ámbar gris (de cachalotes), sebo (de vaca) y plástico (como microesferas o teflón).
¿Pueden vivir ácaros en mis brochas de maquillaje?
Sí, los ácaros Demodex, que viven naturalmente en la piel, pueden transferirse a tus brochas y esponjas.
Conclusión
La salud de tu piel y ojos está directamente relacionada con la higiene de tus herramientas y la calidad de tus productos de maquillaje. Ser consciente de los microbios que pueden proliferar en ellos y de la importancia de su limpieza y reemplazo regular es fundamental. Igualmente, informarse sobre los ingredientes que componen tus cosméticos te permite tomar decisiones más alineadas con tus valores y preocupaciones de salud y ética. Una rutina de belleza segura y saludable va más allá de la aplicación; comienza con la limpieza y el conocimiento de lo que hay en tu neceser.
Si quieres conocer otros artículos parecidos a Secretos Ocultos en Tu Maquillaje puedes visitar la categoría Maquillaje.
